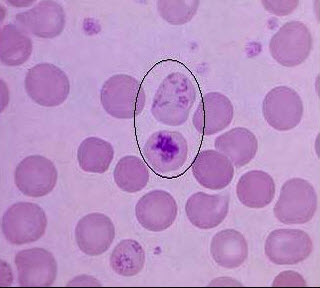

如图,圈中所示红细胞绝对值减少见于下列哪些疾病()
A .巨幼细胞贫血
B .遗传性球形红细胞增多症
C .缺铁性贫血
D .再障
E .PNH
[多选题] 如图,圈中所示红细胞绝对值减少见于下列哪些疾病()A . 巨幼细胞贫血B . 遗传性球形红细胞增多症C . 缺铁性贫血D . 再障E . PNH
[多选题]如图,圈中所示红细胞绝对值减少见于下列哪些疾病()A.巨幼细胞贫血B.遗传性球形红细胞增多症C.缺铁性贫血D.再障E.PNH
[多选题]如图,圈中所示红细胞绝对值减少见于下列哪些疾病()A.巨幼细胞贫血B.遗传性球形红细胞增多症C.缺铁性贫血D.再障E.PNH
[多选题]如图,圈中所示红细胞绝对值减少见于下列哪些疾病()A.巨幼细胞贫血B.遗传性球形红细胞增多症C.缺铁性贫血D.再障E.PNH
[多选题]如图,圈中所示红细胞绝对值减少见于下列哪些疾病()A.巨幼细胞贫血B.遗传性球形红细胞增多症C.缺铁性贫血D.再障E.PNH
[多选题]如图,圈中所示红细胞绝对值减少见于下列哪些疾病()A.巨幼细胞贫血B.遗传性球形红细胞增多症C.缺铁性贫血D.再障E.PNH
[多选题]如图,圈中所示红细胞绝对值减少见于下列哪些疾病()A.巨幼细胞贫血B.遗传性球形红细胞增多症C.缺铁性贫血D.再障E.PNH
[单选题,A2型题,A1/A2型题] 网织红细胞绝对值减少见于()。A . 再生障碍性贫血B . 溶血性贫血C . 急性大出血D . 铁剂治疗1周后E . 缺铁性贫血
[单选题]淋巴细胞绝对值减少见于A.再生障碍性贫血B.流行性腮腺炎C.血管神经性水肿D.结核病E.长期接触放射线
[单选题]淋巴细胞绝对值减少见于( )。A.再生障碍性贫血B.流行性腮腺炎C.血管神经性水肿D.结核病E.长期接触放射线